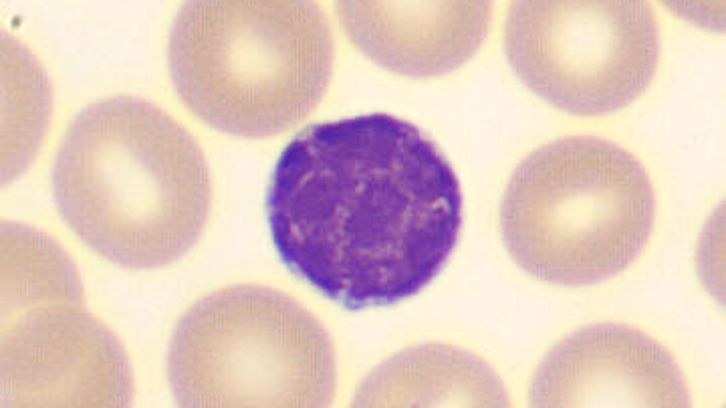
llc atipica

Overusers in general practice
In general practice, overusers, as the name indicates, are patients who overuse or abuse public health services thus generating burnout in professionals and increasing healthcare costs. In this article, the differential personality characteristics of overusers have been analyzed and results have shown...